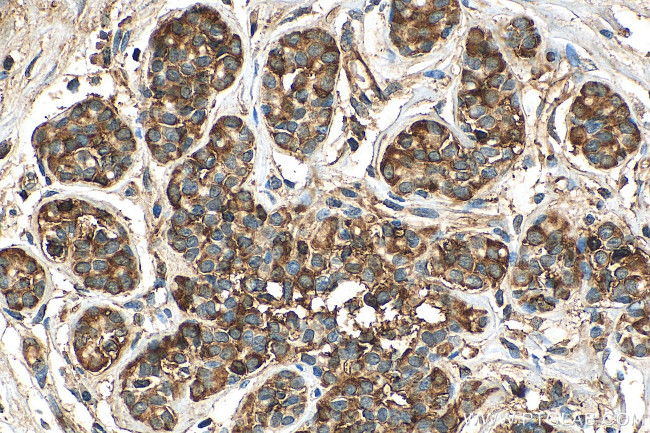
C8G Antibody in Immunohistochemistry (Paraffin) (IHC (P))

Search
Proteintech
C8G Polyclonal Antibody
{{$productOrderCtrl.translations['antibody.pdp.commerceCard.promotion.promotions']}}
{{$productOrderCtrl.translations['antibody.pdp.commerceCard.promotion.viewpromo']}}
{{$productOrderCtrl.translations['antibody.pdp.commerceCard.promotion.promocode']}}: {{promo.promoCode}} {{promo.promoTitle}} {{promo.promoDescription}}. {{$productOrderCtrl.translations['antibody.pdp.commerceCard.promotion.learnmore']}}
产品信息
27200-1-AP
种属反应
宿主/亚型
分类
类型
抗原
偶联物
形式
浓度
规格
纯化类型
保存液
内含物
保存条件
运输条件
产品详细信息
Immunogen sequence: MLPPGTATLL TLLLAAGSLG QKPQRPRRPA SPISTIQPKA NFDAQQFAGT WLLVAVGSAC RFLQEQGHRA EATTLHVAPQ GTAMAVSTFR KLDGICWQVR QLYGDTGVLG RFLLQARGAR GAVNVVVAET DYQSFAVLYL ERAGQLSVKL YARSLPVSDS VLSGFEQRVQ EAHLTEDQIF YFPKYGFCEA ADQFHVLDEV RR
靶标信息
C8G is one of the three polypeptides that constitute C8, a component of the complement system. C8 participates in the formation of Membrane Attack Complex (MAC). Patients with deficiency in C8 are vulnerable to certain bacteria infection.
仅用于科研。不用于诊断过程。未经明确授权不得转售。
篇参考文献 (0)
生物信息学
蛋白别名: complement component 8, gamma polypeptide; Complement component C8 gamma chain; complement component C8-gamma precursor; complement protein C8 gamma subunit precursor
基因别名: C8C; C8G
UniProt ID: (Human) P07360
Entrez Gene ID: (Human) 733